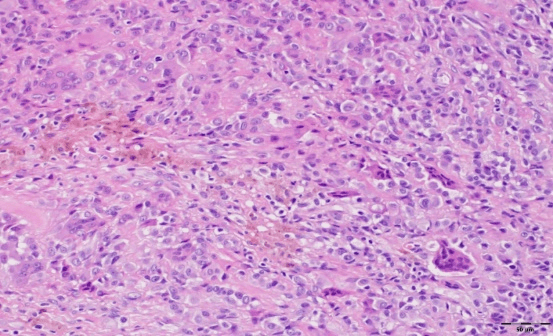
Science Repository

Tenosynovial Giant Cell Tumor in the Tibial Attachment of the Anterior Cruciate Ligament: A Case Report
A B S T R A C T
Tenosynovial giant cell tumors (TGCTs) are a group of rare, benign tumors that involve the synovium, bursae and tendon sheath and arise from the synovial tissue of the tendon sheath. Here, we reported a 21-year-old male patient with a 4-year history of mild pain in his right knee. Magnetic resonance (MR) study revealed a well-defined solid mass which was successfully excised by arthroscopic surgery. No recurrence was observed after 6 months of follow up. This is a first of its kind case report of a (TGCT) arising from the tibial attachment of the anterior cruciate ligament (ACL).
Keywords
Giant cell tumors, knee, anterior cruciate ligament
Introduction
Tenosynovial giant cell tumor (TGCT) is a benign neoplasm arising in the synovial tissues of the tendon sheath, mucosal bursae, and joint [1]. The neoplasm derives from the recruitment of macrophages which forms the mass [2]. It has been calculated that approximately 43 per million presents with TGCT globally, mainly the localized type [3]. Clinical presentation usually begins with painless swelling, edema or growing pain develops with tumor growth [4]. TGCT most predominantly affects the hand (85%) and is generally intra-articular [4]. Surgical excision is generally the preferred therapeutic options [5]. To the best of our knowledge, this is the first case reporting a localized TGCT arising from the tibial attachment of the anterior cruciate ligament in a 21-year-old male patient.
Case Report
A 21-year-old male patient presented to our orthopedic department with a 4-year history of vague right knee pain. The patient’s pain was aggravated while climbing the stairs and squatting. He denied any previous trauma to the knee and he had no complaints of instability. On physical examination, there was no swelling or tenderness over the joint line, the range of motion was full, and pivot shift test and Lachman test were negative. Routine blood test results were unremarkable, X-ray views of the knee were unremarkable, and the T1 and T2 weighted magnetic resonance imaging (MRI) revealed a well-circumscribed solid lesion, measuring about 14×11 mm, arising from the tibial attachment of the anterior cruciate ligament (ACL) (Figure 1).
Figure 1: A-D) MRI of the right knee joint showed a well circumscribed mass, which is localized on the tibial attachment of the anterior cruciate ligament. In T2W MRI (A & C) the signal intensity of the tumor was hyperintense. While, in T1W MRI (B & D) the tumor showed an isointense signal compared to muscle. MRI= magnetic resonance imaging.
Figure 2: Macroscopic appearance of single white-brownish rubbery oval mass located on the tibial attachment of anterior cruciate ligament, measuring about 15×10 mm.
Arthroscopic examination showed an oval-shaped rubbery mass, measuring about 15mm×10mm in diameter, white-brownish in color, located at the tibial attachment of the ACL, and no other masses were found (Figure 2). The single lesion was excised using a shaver and bipolar radiofrequency ablation device. Further arthroscopic examination showed an intact cruciate ligament, menisci, and cartilage. Histopathological examination revealed the presence of mononuclear cells with scattered multinucleated giant cells and foci of fibrous stroma (Figure 3).
Figure 3: Histopathological examination of tenosynovial giant cell tumor sample using a hematoxylin and eosin stain demonstrating round to oval mononuclear cells with scattered multinucleated giant cells.
Postoperatively, the patient was doing well, and he had no further complaints. There was no recurrence at 6-month follow-up.
Discussion
TGCTs are benign, well-defined proliferation of mononuclear cells with a mixture of hemosiderin-laden histiocytes, osteoclast-like giant cells, and other inflammatory cells arising from bursae, synovium, and tendon sheath [1]. The pathogenesis is unclear despite studying many potential pathways such as traumatic, neoplastic, and inflammatory pathways. However, recent studies suggest that the proliferation is driven by overexpression of colony-stimulating factor 1 receptor (CSF-1R) due to specific translocation t (2:1) resulting in the recruitment of CSF-1R expressing cells such as giant cells, osteoclasts, and macrophages [6]. In this case study, we have reported for the first time a case of TGCT in the tibial attachment of the ACL. The most common localizations for this type of tumor are hand and knee [2].
TGCT is the most common tumor of the hand after ganglion cyst [7]. Of the large weight-bearing joints, the knee is most often involved, followed by the hip, ankle, shoulder and elbow [8]. The case we studied, presented with a single nodule in his knee as also revealed by MRI image analysis. TGCTs can be found as a single nodule or multiple noduli. The localized single nodule type is indolent and tends to present in radial digits, whereas the diffuse multiple noduli type involves proliferation in the synovium in and around the knee, has a local aggressive behavior, and tends to be more destructive [4, 9]. TGCTs can affect all age groups, but females (2:1) in their 30s and 40s are the most affected. The overall annual incidence in Europe is still undetermined, while in the US, it was estimated in 1980 to be 11 cases per million inhabitants [10, 11].
The patient presented with vague knee pain that had been present from the last 4 years. Clinical presentation is usually non-specific and can mimic any other mono-articular pathology in these types of patients. Hence, the diagnosis due to the variety of clinical symptoms might be difficult, as the patient may complain of discomfort, vague pain, clicking sensation or swelling of the affected joint [12]. Moreover, the complaints may increase as the disease progresses.
The diagnosis was mainly based on the histopathological features of the specimen and MRI. Nowadays, MRI of the affected joint is widely implemented for the diagnosis and follow-up of the diseases. The localized type of TGCTs appears as low signal area in T1 and T2 weighted images due to iron storage complex hemosiderin deposition in proliferative synovial tissues, while the diffuse type appears as multiple villous projections in the affected joint [13].
Conclusion
TGCTs should be considered in the differential diagnosis of intra-articular solid masses appearing as low signal areas in T1 and T2 weighted MRI images; such cases may present severe knee pain and locking, and the physical examination may even lead to the detachment of the tumor. Local excision of the tumor, either open or arthroscopic, is considered the mainstay of the treatment for these types of cases.
Author Contributions
Loiy Alkhatib and Ralf Kraus participated in the care of the patient. Loiy Alkhatib drafted the manuscript. Scott Sigmann assisted in the review of the literature and in revising the manuscript. All authors read and approved the final manuscript.
Article Info
Article Type
Case ReportPublication history
Received: Mon 09, Mar 2020Accepted: Sat 28, Mar 2020
Published: Mon 30, Mar 2020
Copyright
© 2023 Loiy Alkhatibm. This is an open-access article distributed under the terms of the Creative Commons Attribution License, which permits unrestricted use, distribution, and reproduction in any medium, provided the original author and source are credited. Hosting by Science Repository.DOI: 10.31487/j.SCR.2020.03.07
Author Info
Loiy Alkhatibm Ralf Kraus Scott A. Sigman Ulrich Stahl
Corresponding Author
Loiy AlkhatibmOrthopedic and Trauma Surgery Department, Klinikum Bad Hersfeld, Bad Hersfeld, Germany
Figures & Tables

References
- Fletcher CD, Bridge JA, Hogendoorn PC, Mertens F (2013) WHO Classification of Tumours of Soft Tissue and Bone. Fourth Edition. Tenosynovial giant cell tumor, localized type/diffuse type. IARC Press 2013: 100-103
- Giustini N, Bernthal NM, Bukata SV, Singh AS (2018) Tenosynovial giant cell tumor: case report of a patient effectively treated with pexidartinib (PLX3397) and review of the literature. Clin Sarcoma Res 8: 14. [Crossref]
- Mastboom MJL, Verspoor FGM, Verschoor AJ, Uittenbogaard D, Nemeth B et al. (2017) Higher incidence rates than previously known in tenosynovial giant cell tumors. Acta Orthop 88: 688–694. [Crossref]
- Monaghan H, Salter DM, Al Nafussi A (2001) Giant cell tumour of tendon sheath (localized nodular tenosynovitis): clinicopathological features of 71 cases. J Clin Pathol 54: 404-407. [Crossref]
- Staals EL, Ferrari S, Donati DM, Palmerini E (2016) Diffuse-type tenosynovial giant cell tumour: current treatment concepts and future perspectives. Eur J Cancer 63: 34-40. [Crossref]
- Cupp JS, Miller MA, Montgomery KD, Nielsen TO, O'Connell JX et al. (2007) Translocation and expression of CSF1 in pigmented villonodular synovitis, tenosynovial giant cell tumor, rheumatoid arthritis and other reactive synovitides. Am J Surg Pathol 31: 970-976. [Crossref]
- Lucas DR (2012) Tenosynovial giant cell tumor: case report and review. Arch Pathol Lab Med 136: 901-906. [Crossref]
- Erler K, Demiralp B, Ozdemir MT, Kaya A, Basbozkurt M (2004) Giant cell tumor of tendon sheath simulating giant cell tumor of bone: report of a case. J Surg Orthop Adv 13: 124-127. [Crossref]
- Ottaviani S, Ayral X, Dougados M, Gossec L (2011) Pigmented villonodular synovitis: a retrospective single-center study of 122 cases and review of the literature. Semin Arthritis Rheum 40: 539-546. [Crossref]
- Ehrenstein V, Andersen SL, Qazi I, Sankar N, Pedersen AB et al. (2017) Tenosynovial Giant Cell Tumor: Incidence, Prevalence, Patient Characteristics, and Recurrence. A Registry-based Cohort Study in Denmark. J Rheumatol 44: 1476-1483. [Crossref]
- Myers BW, Masi AT (1980) Pigmented villonodular synovitis and tenosynovitis: A clinical epidemiologic study of 166 cases and literature review. Medicine (Baltimore) 59: 223-238. [Crossref]
- Gelhorn HL, Tong S, McQuarrie K, Vernon C, Hanlon J et al. (2016) Patient-reported Symptoms of Tenosynovial Giant Cell Tumors. Clin Ther 38: 778-793. [Crossref]
- Cheng XG, You YH, Liu W, Zhao T, Qu H (2004) MRI features of pigmented villonodular synovitis (PVNS). Clin Rheumatol 23: 31-34. [Crossref]
